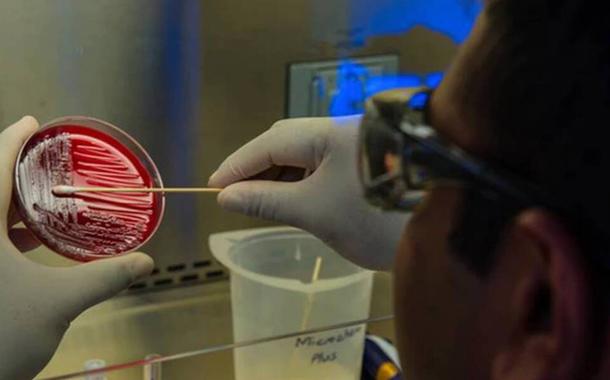

Variante ômicron pode estar levando crianças a serem internadas na África do Sul
Cientistas sul-africanos disseram ainda não ser possível confirmar um vínculo entre a ômicron e a elevação no número de internações de crianças, mas dados mostram presença atípica desta faixa...